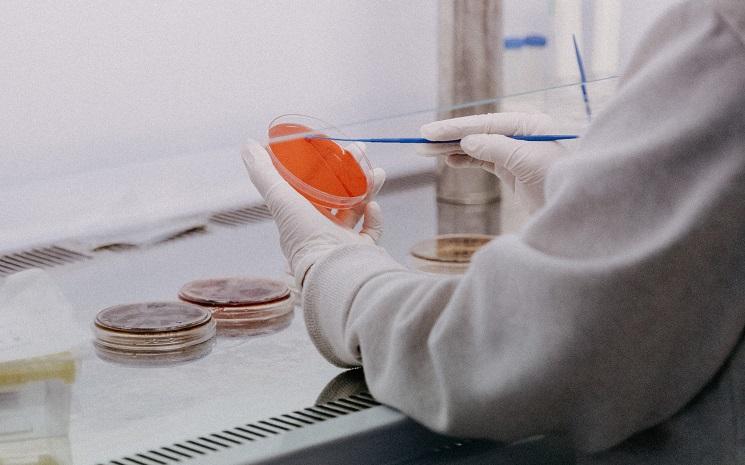
Covid-19 : C.37, un possible variant péruvien ?

Le 3 mai est la journée mondiale de la liberté de la presse, l'occasion d'informer le public à propos des violations du droit à la liberté d'expression. Qu’en est-il au Pérou ?
Article 19 de la Déclaration universelle des droits de l'homme de 1948 : « Tout individu a droit à la liberté d'opinion et d'expression, ce qui implique le droit de ne pas être inquiété pour ses opinions et celui de chercher, de recevoir et de répandre, sans considérations de frontières, les informations et les idées par quelque moyen d'expression que ce soit ».
La liberté de la presse est considérée comme une pierre angulaire des droits humains, comme une assurance qui permet aux autres droits d’être respectés. Elle favorise la transparence, une bonne gouvernance et représente, pour la société, la garantie d’une véritable justice.

La journée mondiale de la liberté de la presse célébrée depuis 1993
La Journée mondiale de la liberté de presse a été instaurée par l'Assemblée générale des Nations Unies en décembre 1993, suite à la tenue du Séminaire qui s'est déroulé à Windhoek (Namibie) en 1991 pour le développement d'une presse africaine indépendante et pluraliste.
Ce séminaire a conduit à l'adoption de la Déclaration de Windhoek qui exigeait l'établissement, le maintien et la promotion d'une presse pluraliste, libre et indépendante. Elle mettait également l'accent sur l'importance d'une presse libre pour le développement économique et la préservation de la démocratie au sein d'un État.
La Journée mondiale de la liberté de presse est célébrée chaque année le 3 mai en hommage à la date à laquelle la Déclaration de Windhoek a été adoptée. Aujourd'hui, dans le monde entier, le 3 mai est devenu l'occasion d'informer le public à propos des violations du droit à la liberté d'expression et le moment de se rappeler que plusieurs journalistes risquent la mort ou la prison en transmettant la nouvelle aux gens.
Selon l'Organisation des Nations Unies pour l'éducation, la science et la culture (UNESCO), qui coordonne chaque année les activités qui soulignent le 3 mai, la Journée mondiale de la liberté de presse, c'est :
- une journée d'action, qui favorise et permet de mettre sur pied des initiatives qui visent la défense de la liberté de la presse.
- une journée d'évaluation, afin de dresser le portrait de la liberté de la presse à travers le monde.
- une journée de rappel, qui permet de rappeler aux États le respect des engagements qu'ils ont pris envers la liberté de la presse.
- une journée d'alerte, pour alerter le public et accroître la sensibilisation à la cause de la liberté de la presse.
- une journée de réflexion, pour stimuler le débat parmi les professionnels des médias sur les problèmes qui touchent la liberté de la presse et l'éthique professionnelle.
- une journée commémorative en mémoire des journalistes qui ont perdu la vie pendant qu'ils exerçaient leur profession.
- une journée d'appui envers les médias qui sont victimes de mesures qui entravent la liberté de la presse ou qui visent à l'abolir.
Le Pérou, 91ème au classement mondial de la liberté de la presse 2021
Cette année, le Pérou perd une place au classement de Reporters Sans Frontières (RSF) par rapport à 2020.
Au Pérou, les journalistes peuvent subir des représailles, parfois sévères, lorsqu’ils couvrent des conflits sociaux ou environnementaux, dénoncent des affaires de corruption ou révèlent les infiltrations du narcotrafic dans les rouages de certaines institutions étatiques. Les lois contre la diffamation représentent la principale menace contre la liberté de la presse : elles sont à l’origine de très nombreuses intimidations et de condamnations de journalistes. Dans les régions rurales et difficiles d’accès, les journalistes qui dénoncent les trafics en tous genres (drogue, bois, etc.) et la corruption sont particulièrement vulnérables.
Il existe par ailleurs un très fort niveau de concentration des revenus et de la propriété des médias, plus particulièrement dans la presse écrite et la presse en ligne. Des difficultés d’accès à l’information et un manque de transparence des autorités publiques ont également compliqué la tâche des journalistes ces dernières années.

Sur le même sujet